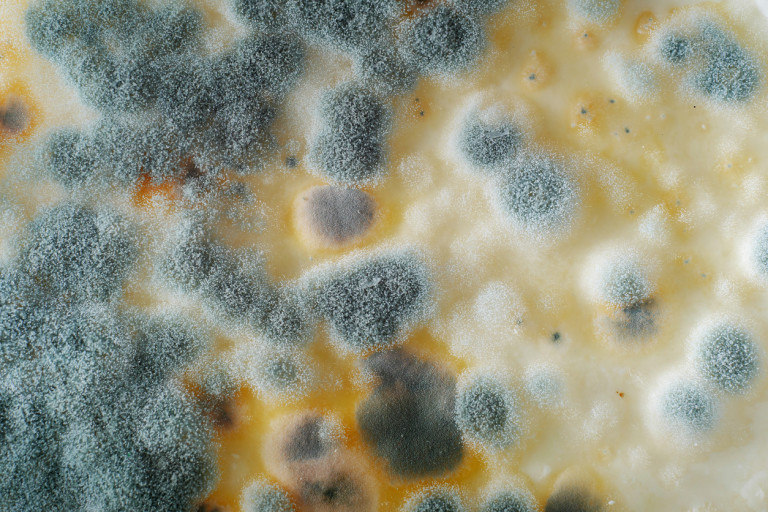

Добре знаем какъв голям проблем е разхищението на храна, но на всеки се е случвало да забрави един или друг хранителен продукт в хладилника или в шкафа и той да се развали. Тогава се замисляме дали не може да отрежем негодната за консумация част и да оползотворим останалото, вместо всичко да отиде на боклука, следвайки правилото, че щом има мухъл, значи вече е негодно. В някои случаи това е възможно, а в други - никак не е препоръчително.
Д-р Кейт Шнайдер, експерт по сигурността на храната от Университета във Флорида, ни дава разяснения кои храни може да консумираме, дори да имат признаци на разваляне, и с кои е по-добре да не рискуваме, защото може да стигнем дори до болница. Тя обяснява, че основната заплаха е невидима - бактерията ешерихия коли, която може да доведе до сериозни здравословни проблеми.
Мухълът е вид гъбичка, която расте естествено върху храна и играе важна роля в разграждането на материята или гниенето. Размножава се чрез производство на спори, които могат да се разпространяват във въздуха, и вирее най-добре в топла и влажна среда. Но не всички видове мухъл са патогенни.
Източник: iStock
Някои са безвредни и могат да бъдат отстранени ефективно чрез изрязване на засегнатия участък. Други обаче водят до производството на микотоксини, които в най-добрия случай могат да причинят стомашни неразположения, а в най-лошия - да доведат до увреждане на органи или развитие на рак.
Тези видове плесени най-често се разпространяват бързо и лесно в меките и полумеките сирена, когато не са съхранявани на достатъчно ниски температури. Тъй като имат по-високо водно съдържание, токсините лесно превземат цялата повърхност, дори това да не е забележимо отвън.
Затова видим ли и най-малката следа, че са тръгнали да се развалят, не бива да правим експерименти със здравето си. Същото правило важи и за киселото мляко - има ли мухъл, изхвърляме го. Най-често меките сирена издържат до около седмица след отваряне на опаковката при съхранение в хладилник.

Източник: iStock
При твърдите ситуацията е малко по-различна - можем да изрежем само засегнатия от мухъл участък и така ще спрем разпространението на опасните вещества. Този тип сирена можем да съхраняваме до три-четири седмици при подходящи условия.
Внимание трябва да обърнем и на плодовете и зеленчуците, по които често се развива опасна, черна плесен, наречена Stachybotrys chartarum. Тя се появява в резултат на микотоксини при съхранение във влажна среда. Те могат да предизвикат различни здравословни проблеми, включително респираторни, алергични реакции, дразнене на кожата и в тежки случаи увреждания на органи или на нервната система.
Затова ако видим черни петна по плодовете и зеленчуците, най-често по доматите, трябва веднага да ги изхвърлим. При тях отново заради високото съдържание на вода е налице лесно разпространение на патогените. Изключение правят може би само морковите и ябълките, защото с обелването можем да премахнем опасните вещества.

Източник: iStock
Мекият хляб също не бива да се консумира при първи признаци на мухлясване. Най-често срещаният вид мухъл върху него се нарича Rhizopus stolonifer. Той се появява като бели или сивкави петна, подобни на козина, по повърхността. Може да произведе спори, които да причинят алергични реакции или респираторни проблеми, пише Daily Mail.
Вероятно ще се изненадаме, но сготвеният ориз и вече сварените яйца трябва да съхраняваме за не повече от 24 часа, и то в хладилник. Затова е добре винаги да си правим сметката при пазаруване и готвене, за да не се окаже след това, че повечето храна отива в кофата.